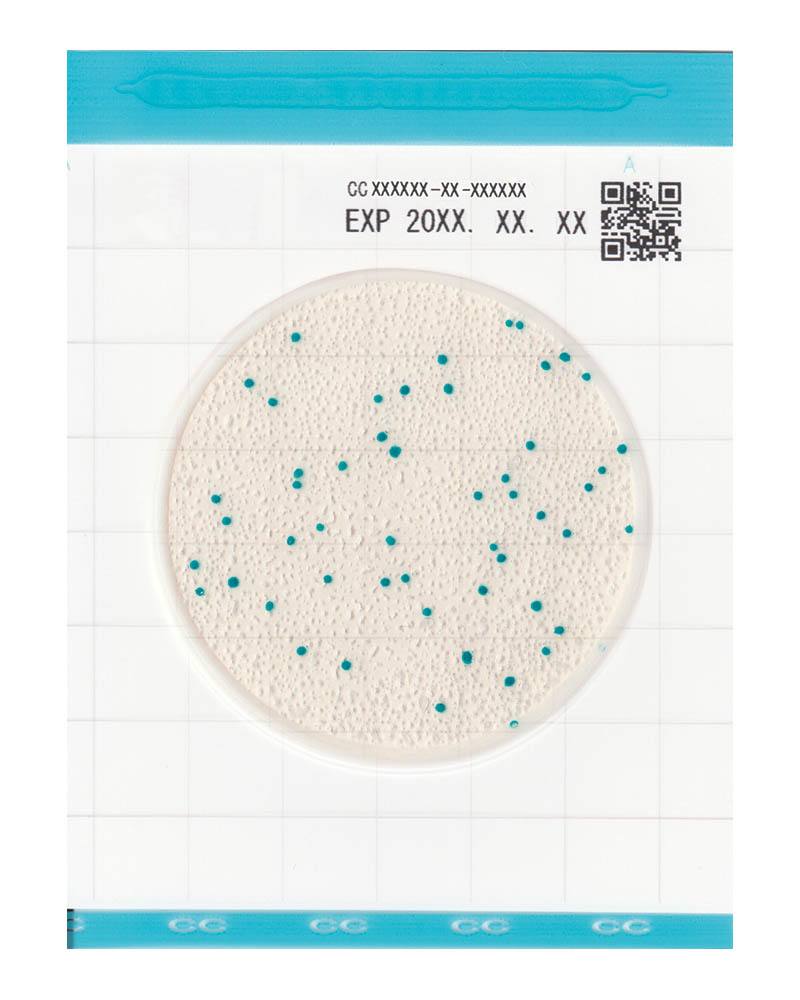
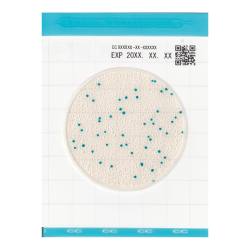
サムネイル
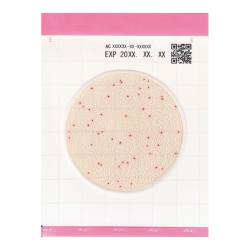
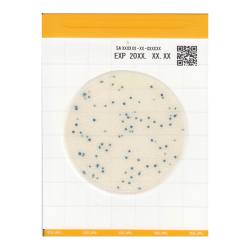
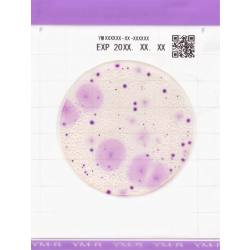

Easy Plate(25枚×40袋) 大腸菌群数測定用 CC
- 冷蔵
●混釈や重層といった操作や特別な治具が不要なので、作業時間が短縮できます。
●重ねながら滴下ができるため、作業時間だけでなく、作業スペースの削減が可能です。
●発色剤により判別が容易なため、検査初心者でも安心して使えます。
コード:3-363-1003
標準価格: ¥ 75,000 (税抜)
標準納期日数
在庫: 取寄品
商品詳細
- 入数
- 1キット(25枚×4袋)×10
- 保存温度
- 冷蔵(2~8℃)
- 規格
- AOACPTM認証取得
- 培養温度
- 35±1℃
- 培養時間
- 24±1時間
同じシリーズの商品が 14 商品あります。
| 商品画像 | 商品番号 | 商品名 | 標準価格 (税抜) |
在庫 | 数量 | |
|---|---|---|---|---|---|---|
| 3-363-1003 | Easy Plate(25枚×40袋) 大腸菌群数測定用 CC |
標準価格 ¥75,000 |
在庫 取寄品 |
数量
|
||
| 3-363-1000 | Easy Plate(25枚×4袋) 一般生菌数測定用 AC |
標準価格 ¥9,500 |
在庫 11 |
数量
|
||
| 3-363-1001 | Easy Plate(25枚×40袋) 一般生菌数測定用 AC |
標準価格 ¥75,000 |
在庫 取寄品 |
数量
|
||
| 3-363-1002 | Easy Plate(25枚×4袋) 大腸菌群数測定用 CC |
標準価格 ¥9,500 |
在庫 8 |
数量
|
||
| 3-363-1004 | Easy Plate(25枚×4袋) 大腸菌・大腸菌群数測定用 EC |
標準価格 ¥13,000 |
在庫 6 |
数量
|
||
| 3-363-1005 | Easy Plate(25枚×20袋) 大腸菌・大腸菌群数測定用 EC |
標準価格 ¥47,500 |
在庫 取寄品 |
数量
|
||
| 3-363-1006 | Easy Plate(25枚×4袋) 黄色ブドウ球菌数測定用 SA |
標準価格 ¥19,900 |
在庫 0 |
数量
|
||
| 3-363-1007 | Easy Plate(25枚×20袋) 黄色ブドウ球菌数測定用 SA |
標準価格 ¥75,000 |
在庫 取寄品 |
数量
|
||
| 3-363-1008 | Easy Plate (25枚×4袋) 真菌(カビ・酵母)数測定用 YM-R |
標準価格 ¥17,500 |
在庫 0 |
数量
|
||
| 3-363-1009 | Easy Plate (25枚×20袋) 真菌(カビ・酵母)数測定用 YM-R |
標準価格 ¥70,000 |
在庫 取寄品 |
数量
|
||
| 3-363-1010 | Easy Plate(25枚×4袋) 腸内細菌科菌群数測定用 EB |
標準価格 販売終了 |
在庫 -- |
|||
| 3-363-1011 | Easy Plate(25枚×20袋) 腸内細菌科菌群数測定用 EB |
標準価格 ¥50,000 |
在庫 取寄品 |
数量
|
||
| 3-363-1012 | Easy Plate(25枚×4袋) 一般生菌数迅速測定用 AC-R |
標準価格 ¥11,000 |
在庫 4 |
数量
|
||
| 3-363-1013 | Easy Plate(25枚×20袋) 一般生菌数迅速測定用 AC-R |
標準価格 ¥45,000 |
在庫 取寄品 |
数量
|